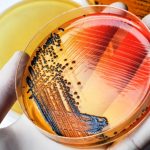
Rischio salmonella: il ministero della salute ritira barrette, croissant e salsicce

Sede dell’evento, in programma lunedì 12 novembre, è il Policlinico Militare di Roma.
Si terrà il prossimo 12 novembre, presso il Policlinico Militare di Roma l’evento ECM dal titolo “Ecografo e Bladder Scanner in ausilio al cateterismo vescicale – Applicazioni in ambito infermieristico”. Il corso erogherà 6.6 crediti ECM ed è registrato al nr. Agenas 1528-242234.
Per qualsiasi informazione è possibile utilizzare i seguenti contatti:
Segreteria organizzativa
Dott.ssa Veronica Siniscalchi
Tel: +39 06.8554149
Email: [email protected] – [email protected]
Website: www.urolorg.it

Lascia un commento